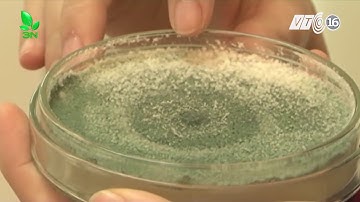
Nấm đối kháng Trichoderma và công dụng tuyệt vời với cây trồng I VTC16

⬇ DOWNLOAD NOW
Kalau muncul iklan pop-up, tutup lalu klik tombol kembali
Download lagu Nấm đối kháng Trichoderma | VƯỜN SINH THÁI secara gratis hanya untuk keperluan promosi. Dukung artis favorit kamu dengan membeli musik original di iTunes atau platform resmi lainnya.
 Nấm đối kháng Trichoderma Bacillus Cực Mạnh | VƯỜN SINH THÁI
Nấm đối kháng Trichoderma Bacillus Cực Mạnh | VƯỜN SINH THÁI
Nấm đối kháng Trichoderma và công dụng tuyệt vời với cây trồng I VTC16
Nấm đối kháng Trichoderma và công dụng tuyệt vời với cây trồng I VTC16
 Nấm đối kháng Trichoderma NANO-gro từ MỸ phòng trị vàng lá thối rễ, héo xanh, chết cây, ủ phân
Nấm đối kháng Trichoderma NANO-gro từ MỸ phòng trị vàng lá thối rễ, héo xanh, chết cây, ủ phân
 5 LƯU Ý QUAN TRỌNG KHI SỬ DỤNG NẤM ĐỐI KHÁNG TRICHODERMA BICILLUS
5 LƯU Ý QUAN TRỌNG KHI SỬ DỤNG NẤM ĐỐI KHÁNG TRICHODERMA BICILLUS
 Nông dân cần biết-hiểu về nấm trichoderma, cách chọn sản phẩm chất lượng và cách ủ tricho tại nhà.
Nông dân cần biết-hiểu về nấm trichoderma, cách chọn sản phẩm chất lượng và cách ủ tricho tại nhà.
 Nấm đối kháng Trichoderma là gì? #trichoderma | Thiên Thảo Hân
Nấm đối kháng Trichoderma là gì? #trichoderma | Thiên Thảo Hân
 Nấm đối kháng trichoderma - thông tin tổng quát, cách nhân sinh khối và sản xuất thương phẩm
Nấm đối kháng trichoderma - thông tin tổng quát, cách nhân sinh khối và sản xuất thương phẩm
 TRICHODERMA LÀ GÌ ? | NẤM ĐỐI KHÁNG TRICHODERMA BẢO VỆ CÂY TRỒNG | Vlog Nông Nghiệp TKS
TRICHODERMA LÀ GÌ ? | NẤM ĐỐI KHÁNG TRICHODERMA BẢO VỆ CÂY TRỒNG | Vlog Nông Nghiệp TKS